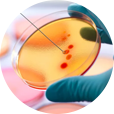
#

Apoyo a Médicos
Atención a Laboratorios

¿Quiénes somos?
Bienvenidos a Genos Medica
Somos un Centro Especializado en Genética, conformado por un grupo de profesionistas certificados por el Consejo Mexicano de Genética A. C. y Miembros de la Asociación Mexicana de Genética Humana A. C.
Dedicamos nuestros esfuerzos para dar un manejo integral a pacientes y familiares con enfermedades hereditarias, por lo que contamos con área de consulta y laboratorio especializado.
En el equipo hay expertos en Genética Médica, Genética Perinatal, Citogenética, Citogenética Molecular, Biología Molecular, Peritos en Genética e Investigadores.
Surgimos ante la necesidad de atender a pacientes con enfermedades genéticas. En México las malformaciones congénitas y alteraciones cromosómicas son la segunda causa de mortalidad infantil.
Tecnología de vanguardia
La amplia colección de pruebas genéticas que ofrece Genos Médica brinda a pacientes y médicos las soluciones para un diagnóstico de certeza.

¡Recibimos muestras de toda la República Mexicana!
Realizamos los estudios en nuestras instalaciones en la Ciudad de México.
Más de 1000 servicios en catálogo
Servicios Actuales
¿Qué es un Médico Genetista?
Trabajamos para ti
Es el médico encargado del abordaje integral de los pacientes con enfermedades genéticas.
A través del estudio de los antecedentes familiares y personales, la exploración física detallada y el apoyo de estudios de laboratorio y gabinete es posible integrar un Diagnóstico Clínico y junto con pruebas especializadas (Técnicas de Citogenética o Biología Molecular) obtener un Diagnóstico de Certeza, a partir del cual se otorga el Asesoramiento Genético.
Asimismo coordina un equipo médico multidisciplinario, brindando una atención integral.
+ de 1000
Tipos de pruebas disponibles
Maquila
a laboratorios
11
Años de experiencia
+ de 50%
de nuestros colaboradores con postgrado
¿Qué es el asesoramiento genético?
El equipo médico
Genos Médica se caracteriza por tener un proceso en el cual se le explica al paciente y a su familia el padecimiento, sus posibles causas, el pronóstico y riesgos de recurrencia a cada individuo de la familia, es decir la posibilidad de tener hijos con el mismo diagnóstico.
Estamos para asesorarte, un servicio que genera confianza entre nuestros usuarios y nos coloca como referencia actual en México.
#SomosGenosMedica
Solicita más información
¿Buscas algún estudio en particular o tienes dudas sobre nuestro servicio?
Dudas o comentarios

























